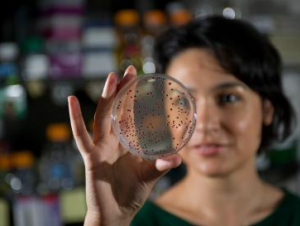

Staff advocacy and advisory group gets ready to meet to address challenges, opportunities for growth
Ann Pearman, Mackenzie Hughes, and Clara Coblenz of the School of Psychology join North Carolina State University researchers in sharing alarming reported symptoms and significant mental health risks.
As we start fall semester and a fresh school year, second year neuroscience major Annabelle Thomas joins Fredrick Holloman, a learning specialist and academic coach in Georgia Tech Tutoring & Academic Support, to share top tips for a successful semester.
A new at-home polysomnography kit, built by Audrey Duarte and W. Hong Yeo, proposes a path to getting data and a better night’s sleep — thanks to a new, unobtrusive nanotech device.
An new app made available to Georgia Tech faculty, staff and students uses smartphones to help control the coronavirus.
Kathryn Lanier (PhD Chem 17), Maria Soto-Giron (PhD BI 18), Nseabasi Ufot (Psy 02) are included in a new program designed to recognize the achievements of Georgia Institute of Technology alumni who are improving the human condition.
GT-ORNL still has funding available for graduate, postdoc students in wide range of disciplines.
Myanna, who joined Georgia Tech as director of the LGBTQIA Resource Center in May, shares insights and advice for students, faculty, and staff looking to connect to resources, forge new friendships, and get involved as advocates and allies.
On behalf of the School of Psychology, we would like to take a moment and congratulate the Class of 2020.
Work by scientists in all six schools earns recognition and continued research opportunities